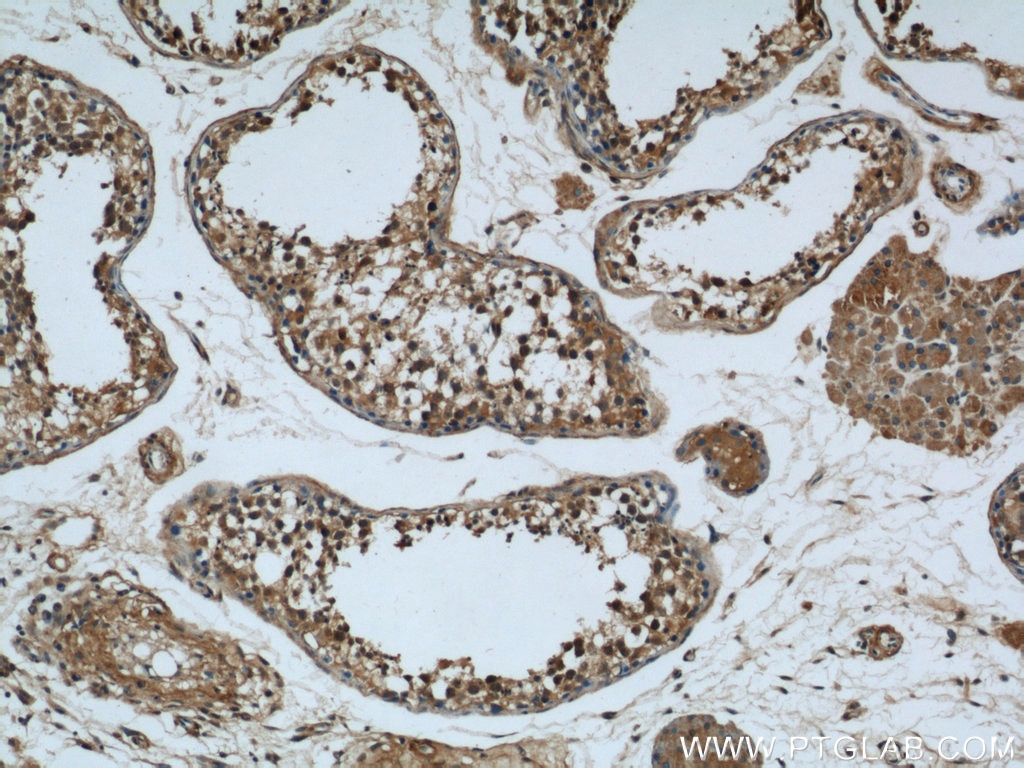
Rubicon Antibody 1 Ap Proteintech

[ベスト] xing the rubicon 161116-Xing the rubicon 意味
Crossing the Rubicon Astounding!"Crossing the Rubicon" became a popular phrase describing a step that definitely commits a person to a given course of action The modern Rubicone (formerly Fiumicino) River is officially identified with the Rubicon that Caesar crossed, but the Pisciatello River to the north and the Uso to the south have also been suggestedCrossing The Rubicon by IceRocks, released 05 March 21 1 Pain & Suffering feat Flee Lord & Madhattan 2 Draft Day feat Rick Hyde & Ren Thomas 3 Kennedy feat Rome Streetz & Madhattan 4 Grandmas feat UFO Fev 5 Fed Time feat Heem 6 Buck Fifty Shave Club feat Skrewtape 7 Red Presidents feat Benny The Butcher & Meyhem Lauren 8

119 Ethans Xing Montgomery Tx Realtor Com
Xing the rubicon 意味
Xing the rubicon 意味-CROSSING THE RUBICON, PART II, By Don R Marsh RENDERING A FINAL SALUTE Out of respect and due to the sensitivity of this article, the names, dates, and hometowns of the soldiers' remains whom I escorted in the years 1947, 1948 and 1949 shall remain anonymousThe Rubicon marked the border between Caesar's province, Cisalpine Gaul to the northeast, and Italy itself Crossing the river meant crossing the border into Italy Crossing the border still in command of your troops, meant breaking the law It meant treason It meant war



Compare Prices For Xing Yu Across All Amazon European Stores
To "cross the Rubicon" means to cross a point of no return It means a person has definitively committed him or herself to a course of action, and there is no turning back Dylan is using the notion of "crossing the Rubicon" in the latter general sense rather than the former historical oneApr 17, · "Crossing the Rubicon" is an example of a clever use of song structure with a Pre Chorus–Chorus–Post Chorus structure The Chorus is the key message, with the Pre Chorus building up to itWhen you look at the values of the culture around us, there is a war that's
No easy task for a reviewer charged with poring over theAnd yet at last, with this Mike Ruppert's beyondcourageous offering we gain sight of the whole of corporatemanaged, governmentassisted, banklaundered, drugfunded plunder And a jolt to spur our movements to take back the world — Chellis Glendinning, PhD, author of ChivaFinally it was time to get back to "normalcy"
The album title "Crossing the Rubicon" is a metaphor for deliberately passing a point of no return, especially when a business of risky consequences is at stake This portrays precisely where NOTES FROM UNDERGROUND stand at present The journey has began — only victory awaits to be fought for, at the other end of the Rubicon riverIn Crossing the Rubicon, Emmanuel Falque seeks to end this faceoff Convinced that "the more one theologizes, the better one philosophizes," he proposes a counterblow by theology against phenomenology Instead of another philosophy of "the threshold" or "the leap"―and through a retrospective and forwardlooking examination of hisCross the Rubicon To commit to a particular plan or course of action that cannot be reversed The phrase refers to how Julius Caesar crossed the Rubicon river and became embroiled in civil war in 49 BCE Look, if you cheat on this test, you are crossing the Rubicon, man


Fen River Irrigation Authority China Rubicon Water



Jeep S Downsizing Four Cylinder Turbo Gasoline Engines In Jeep Wrangler And Jeep Cherokee Springerprofessional De
Crossing the Rubicon Historical Allusion Summary The phrase "Crossing the Rubicon" originates from the historic event of Julius Caesar In 49 BCE, a man by the name of Julius Caesar was a governor of Gaul, part of modernday France He was faced with a derogatory and complicated conundrum, it was illegal to enter italy which if he did, he would become a miscreant and cause aMar 24, 21 · "Crossing the Rubicon" became a popular phrase describing a step that definitely commits a person to a given course of action I found a few explanations that bring us a little farther back in time from A Dictionarie of the French and English Tongues , compiled by Randle Cotgrave and originally published in 1611Dec 21, · Crossing the Rubicon December 21, December 21, Culture / History / Nationalism / Politics 7 mins read In the days and weeks since the election there have been a million different stories covering a million different theories on what is going on, and what is going to happen Some of them seem credible, some farfetched


J902 Technic Car Series Moc 2425 G63amg 6x6 Land Cruiser Model Building Blocks Bricks Kids Toys For Children



仮面ライダーアマゾンズ シーズン2 Episode 11 Xing The Rubicon のあらすじが判明 ネオ クラゲアマゾンがラスボス
Have we reached the point of no return?THE ORIGINS OF "CROSSING THE RUBICON" A SHORT HISTORY LESSON TO APPRECIATE "CONSEQUENCE OF ACTION" On or about January 10th in the year 49 BCE, in the northern Italian peninsula, on the banks of the Rubicon River that represented the legal border in the Republic of Rome from its territories, stood a man, a general, named Gaius Julius CaesarNov , · The Rubicon Primaris is a name given for an extensive operation, that allows Space Marines to be reborn as Primaris Space Marines



仮面ライダーアマゾンズ Season2 Episode11 Xing The Rubicon 感想 考察 レイジング野郎



New 21 Jeep Wrangler For Sale Bangor Ellsworth Augusta Me
Dec 21, · Colloquially, "crossing the Rubicon" means something like moving past the point of no return, which is ominous enough when it comes to pushing to overthrow a democratic electionJun 12, 09 · Crossing the Rubicon is a much better album if you don't think much about it;Mar 30, 21 · That idea of crossing the Rubicon is reaching the point of no return There is no going back It's become known for that very thought, point of no return And when you think about it, have we as a society crossed the Rubicon?


Brandmaker Announces Strategic Investment From Rubicon


Rubicon Agentur Fur Markendesign Gmbh Informationen Und Neuigkeiten Xing
Jul 15, 19 · To cross the Rubicon is a metaphor which means to take an irrevocable step that commits one to a specific course When Julius Caesar was about to cross the tiny Rubicon River in 49 BCE, he quoted from a play by Menander to sayCrossing the rubicon, part i, By Don R Marsh The "war to end all wars" was over, the welcome home parades and merriment of the returning servicemen had long come to close;On the Rubicon crossing we have corroborating physical evidence, and we know several contemporaries wrote on the war and thus provided direct or indirect evidence for the crossing Apart from the direct testimony of Caesar himself, we have the letters of Cicero and his friends, and the letters he had from Caesar and Pompey, and we know Livy



Iflight 4pcs Xing Nano 1105 6000kv 2 3s Fpv Brushless Motor For Micro Quadcopter Racing Unibell Remote App Controlled Vehicles Parts Toys Games



Axial Scx10 Jeep Wrangler Rubicon Online Shopping
Crossing the Rubicon is the story of seven remarkable teens as they survive the unbelievable What started out as a simple weekend trip exploring the Chungo caves, became a journey which took them back 275 years in time, had them cross multiple continents, and stretched them to their limits Discover how they survived with just the clothes onNov 25, · Julius Caesar's crossing of the Rubicon River with his army was an event in January 49 BC that precipitated the Roman Civil War and ultimately led to Caesar becoming dictator It led to the rise of the imperial era of Rome and changed the world Today, the phrase "crossing the Rubicon" is a metaphor that means to pass a point of noCrossing the Rubicon Book Description A dramatic account of the fateful year leading to the ultimate crisis of the Roman Republic and the rise of Caesar's autocracy When the Senate ordered Julius Caesar, conqueror of Gaul, to disband his troops, he instead marched his soldiers across the Rubicon River, in violation of Roman law



Dawn M Krueger 262 966 0096 N66w Lappland Xing Oconomowoc Wi Nuwber


Crossing The Rubicon Wikipedia
Crossing the Rubicon provides an exemplary model that enables dialogue across difference, though such a movement also exposes a necessary inner tension that appears irresolvable in the relationship between philosophy and theology—a mutual necessity but also a mutual hostility or antagonism, or (at best) a mutual opposition and critiqueXING THE RUBICON is the twentyfourth episode of Kamen Rider Amazons Transcript Maddy Hi, I'm Maddy Fisher and this is Crossing the Rubicon, SPAs poetry podcast In this episode, I will be interviewing English teacher Philip de Sa e Silva about his experience with poetry de Sa e Silva I'm Philip de Sa e Silva I am an English teacher at SPA and my pronouns


Mitarbeitende Von Rubicon Gummitechnik Und Maschinenbau Gmbh Xing

Rubicon Antibody 1 Ap Proteintech
Nov 04, · Caesar's crossing of the Rubicon In one of the most iconic moments of Caesar's biography, in 49 BCE the general — under orders from the Roman Senate to disband his armies — made the coldblooded decision to lead his army across the Rubicon river into Italy This plunged the Roman world into civil warMar 18, 21 · From Wikipedia com "Julius Caesar's crossing the Rubicon river on January 10, 49 BC precipitated the Roman Civil War, which ultimately led to Caesar's becoming dictator and the rise of the imperial era of Rome" "He was explicitly ordered not to take his army across the Rubicon river, which was at that time a northern boundary of ItalyJan 08, 21 · The Rubicon river is a short, shallow river of little importance about 0 miles northwest of Rome The Roman Empire had a law that forbade any Roman military general leading a standing army from crossing the Rubicon River and entering Italy proper



Crab Crossing Xing Sign New



Xing The Rubicon By Epicentre
Aug 18, · In the sight of the Senate, crossing the Rubicon River with his army would be viewed as an act of treason – an insurrection, and according to Roman law, an act of war The Rubicon River was the northern boundary of Italy However, in 49 BC, in defiance of the Roman Senate, Caesar brought his army across the Rubicon River headed towards RomeCrossing the Rubicon is one of those rare books capable of ruining a reviewer's credibility by seducing the superlatives out of him It is, however, open to another interpretation Sure, Cheney accords Halliburton hallowedground status But to many, the American way of life, which Cheney declares is "not negotiable," is an end that moreCrossing The Rubicon is a IPA American style beer brewed by Drygate Brewery in Glasgow, GB6, United Kingdom Score 85 with 11 ratings and reviews Last update



New Honda Fourtrax Rubicon Eps 710 E Grand Xing Mobridge South Dakota Hammer S Honda



4 Buah Set Gloss Rubicon Hood Decals Stiker Cj Yj Tj Jk Wrangler Gratis S H Decal 15cm Stiker Aliexpress
To commit to a particular plan or course of action that cannot be reversed The phrase refers to how Julius Caesar crossed the Rubicon river and became embroiled in civil war in 49 BCE Look, if you cheat on this test, you are crossing the Rubicon, man You can't take that backPublished in 04, Crossing the Rubicon The Decline of the American Empire at the End of the Age of Oil by Michael C Ruppert, remains a book of great historic significance Close to 700 pages long with over 1,000 footnotes, it is a testament to Ruppert's years of exemplary service as a detective and investigative journalistOriginal lyrics of Crossing The Rubicon song by Bob Dylan Explore 1 meaning and explanations or write yours Find more of Bob Dylan lyrics Watch official video, print or download text in PDF Comment and share your favourite lyrics



Stock New 21 Honda Trx5fa6 710 E Grand Xing Mobridge South Dakota Hammer S Honda



Fabian Schmied Software Architect For Signpath And Signpath Io Rubicon It Gmbh Xing
Directed by Grant Olson With Greta Banning, Steve Cuthbert, Andrew Goodwin, Elizabeth Hanson Trevor Harrington is so brilliant, he has been identified as a new human species Fortunately, he still has the twentythree chromosomes necessary to breed with humans In order to propagate this species, the Goodman Institute recruits a young girl, Ruby Crawford, to be his breeding partnerTe mostramos la letra de La canción Crossing the Rubicon (Cruzando el Rubicón), en inglés y traducida al castellano Si siempre quisiste saber qué decía el tema Crossing the Rubicon, descúbrelo aquí Crossing the Rubicon I crossed the Rubicon on the 14th dayCrossing the Rubicon Written by Bob Dylan I crossed the Rubicon on the 14th day of the most dangerous month of the year At the worst time at the worst place that's all I seem to hear I got up early so I could greet the Goddess of the Dawn I painted my wagon I abandoned all hope and I crossed the Rubicon


가면라이더 아마존즈 2기 11화 Xing The Rubicon 돌아갈 수 없는 길을 건너다 네이버 블로그


Faqs Rubicon Trail Jeep Tours
Crossing the Rubicon When Julius Caesar crossed the Rubicon River in 49 BC, he broke an ancient law forbidding any general to enter Italy with an army—thus making war with Rome inevitable Ever since, "crossing the Rubicon" has come to symbolize a point of no return, when the time for deliberation is over and action is at handOne clear example of "Rubicon" action is the deliberate taking of human life Once a person's life is destroyed, he is deprived of everything he has—or ever will have, including all future opportunities, as far as earthly life is concerned And there is no reversing thatNow we're crossing the Rubicon We tried everything under the sun So we're crossing the Rubicon Cos it's too late, it's too late Fill me out a prescription For this existential dread I woke up into a nightmare And I'm hoping that you'll take me back to bed But we can't turn back it's a labyrinth Now the die is cast my friend (we endeavour)



三浦孝太 11話 Xing The Rubicon 数時間後配信開始 是非ともご覧ください 写真は黒崎と本田 本田の得意技は左ミドルキック かなw 本田役の大樹はムードメーカーでした 感謝しかないですね しかし黒崎隊はバラバラになってゆくなー 黒崎隊



Daniel Hermann Techniker Gebaudeautomation Rubicon It Gmbh Xing
Feb 16, 21 · Refers to Julius Caesar's crossing of the Rubicon River to wage civil war with Rome, on January 10, 49 BC, in violation of law Suetonius' use of the phrase the die is cast in describing this act popularised the use of that phrase, which was first attributed toTaken from Enter Shikari's new album 'Nothing Is True & Everything Is Possible' out now https//orcdco/nothingistrueWebsite http//wwwentershikaricomICrossing the Rubicon A Novel of War and millions of other books are available for Amazon Kindle Learn more Books › Literature & Fiction › Genre Fiction Kindle $999 Hardcover $4109 Paperback $2399 Other sellers & formats from $999 Price New from Used from Kindle "Please retry" $999 — — Hardcover


1941 Pcs Le J902 Jeep Wrangler Rubicon Bricks



Jeep Jl Wrangler Jt Gladiator Truck Amfib Snorkel By Rugged Ridge How To Installation Youtube


Xing The Rubicon Youtube



On The Rubicon Trail



Dipl Ing Thomas Kuhta Senior Principal Consultant Rubicon It Gmbh Xing



Pin By Mauricio Rueda On Jeep Wrangler Unlimited Jeep Wrangler Unlimited Jeep Gladiator Jeep Life



Xing Band Page 1 Line 17qq Com


The Effects Of Rubicon Knockdown On Autophagy A Double Knockdown Of Download Scientific Diagram



Dog Sign Dog Crossing Dog Xing Garden Sign Stake Etsy



仮面ライダーアマゾンズ シーズン2 Episode 11 Xing The Rubicon の予告 千翼は自分が生きるためにイユと戦う決意をする


Kamen Rider Amazons Season 2 Internet Movie Firearms Database Guns In Movies Tv And Video Games


Crossing The Rubicon Wikipedia



Way To Nowhere Kamen Rider Wiki Fandom



Marisol Pfohl Vasquez Vertriebsmitarbeiter Rubicon Gummitechnik Und Maschinenbau Gmbh Xing


Xing The Rubicon Kamen Rider Wiki Fandom



仮面ライダーアマゾンズ シーズン2 Episode11 Xing The Rubicon 東映 テレビ



Amazon Riders Xing The Rubicon Sparklight



X Ing The Rubicon Clean By Meck On Amazon Music Amazon Com



Home Igotajeep



仮面ライダーアマゾンズ シーズン2 Ep11 Xing The Rubicon レビュー 壮絶な親子喧嘩やん ぱぐネスト



Kamen Rider Amazons 2x11 Xing The Rubicon Trakt Tv



Xing The Rubicon Kamen Rider Wiki Fandom



Johannes Baumeister Niederlassungsleiter Rubicon Personalmanagement Gmbh Xing


The Role Of Rubicon In Autophagosome Maturation And Endocytic Download Scientific Diagram



21 Jeep Wrangler 4xe Phev First Look Autotrader


Xing Hui Che Mo Benz Bigg63 Amgremote Control Automobile May Open The Doorusbrechargeable Off Road Vehicle Children S To Shopee Malaysia



Yap Lv5pyhqhim



Xing The Rubicon By Epicentre



Rich German Heritage Welcoming Community Distinguish St John Rubicon Catholic Herald



アマゾンネオ Episode11 Xing The Rubicon tube 仮面ライダー隊新聞rx



J902 Technic Car Series Moc 2425 G63amg 6x6 Land Cruiser Model Building Blocks Bricks Kids Toys For Children



Jeep Lifestyles With The All New 18 Wrangler Fit Fathers



仮面ライダーアマゾンズ シーズン2 Episode11 Xing The Rubicon 東映 テレビ


Prof Xing Yi Ling From Nanyang Technological University Visited School Of Chemical And Material Engineering 金沙澳门官网网址cow中文站


History Of The Phrase Crossing The Rubicon The Greek Myths


Fen River Irrigation Authority China Rubicon Water



Compare Prices For Xing Yu Across All Amazon European Stores



Xing Band Page 1 Line 17qq Com


New 21 Jeep Wrangler Rubicon 392 Oregon Adventure Rentals



Iflight 4pcs Xing Nano 1105 6000kv 2 3s Fpv Brushless Motor For Micro Quadcopter Racing Unibell Remote App Controlled Vehicles Parts Toys Games


Kamen Rider Amazons Season 2 Internet Movie Firearms Database Guns In Movies Tv And Video Games


X Rubicon Experiences Reviews


仮面ライダーアマゾンズ シーズン2 Episode11 Xing The Rubicon 東映 テレビ



Xing Band Page 1 Line 17qq Com


Rubicon Food Products Ltd Informationen Und Updates Xing


Rubicon Gmbh Informationen Und Neuigkeiten Xing



Tv Time Kamen Rider Amazons S02e11 Xing The Rubicon Tvshow Time



Pin On Cars Cars



仮面ライダーアマゾンズ Season2 Episode11 Xing The Rubicon 感想 考察 レイジング野郎


仮面ライダーアマゾンズ シーズン2 第11話 Xing The Rubicon 感想 30cal Clubレビュー



Friends Of The Rubicon Fotr Home Facebook



仮面ライダーアマゾンズ Xing The Rubicon 17



Mitarbeitende Von Rubicon It Gmbh Xing



仮面ライダーアマゾンズ シーズン2 Episode11 Xing The Rubicon 東映 テレビ



119 Ethans Xing Montgomery Tx Realtor Com


仮面ライダーアマゾンズ シーズン2 Episode11 Xing The Rubicon ドラマ Gyao ストア



Jeep Rubicon Jeep Cars Background Wallpapers On Desktop Nexus Image



第11話 Xing The Rubicon 高木勝也オフィシャルブログ Log Book Powered By Ameba



M U𝑵𝑬 アマゾンズ シーズン2 Episode11 Xing The Rubicon 自分を守る為に 好きな人と一緒になる為に 好きな人と対決する 仮面ライダーアマゾンズシーズン2 アマゾンズ Amazons 千翼 イユ 切ない T Co Nihzclir9j



Compare Prices For Long Xing Across All Amazon European Stores



Bs6 Suzuki Gixxer Jeep Wrangler Rubicon Mercedes Benz E Class


Localization Of Rubicon A A549 Cells Transfected With A Gfp Rubicon Download Scientific Diagram



仮面ライダーアマゾンズ シーズン2 Episode 11 Xing The Rubicon の予告 千翼は自分が生きるためにイユと戦う決意をする



Kamen Rider Amazons Season 2 Episode 11 Ozc Live



仮面ライダーアマゾンズ シーズン2 Episode11 Xing The Rubicon ネタバレ感想まとめ ニチアサエイト


Rubicon Gmbh Gesellschaft Fur Organisations Und Personalentwicklung Informationen Und Neuigkeiten Xing



アマゾンネオ Episode11 Xing The Rubicon tube 仮面ライダー隊新聞rx



Mag Stefanie Zankl Team Lead Product Consulting Rubicon It Gmbh Xing



Xing The Rubicon Kamen Rider Wiki Fandom


Automotive Lift Kits Parts Rubicon Express Adj Track Bar Jeep Wrangler Jk Rear Re1690 R Ere1690



42 Puckett Creek Xing Murfreesboro Tn Mls Redfin



Lindita Ferati Personalberater Rubicon Personalmanagement Gmbh Xing



Amazon Com Sdkfz 250 1 Neu Aka 250n 1 56th Scale 28mm Toys Games


Rubicon Personalmanagement Gmbh Informationen Und Neuigkeiten Xing



Never Get Lost In The Verse Again Firefly



Rainier Peak Xing Conroe Tx Realtor Com


コメント
コメントを投稿